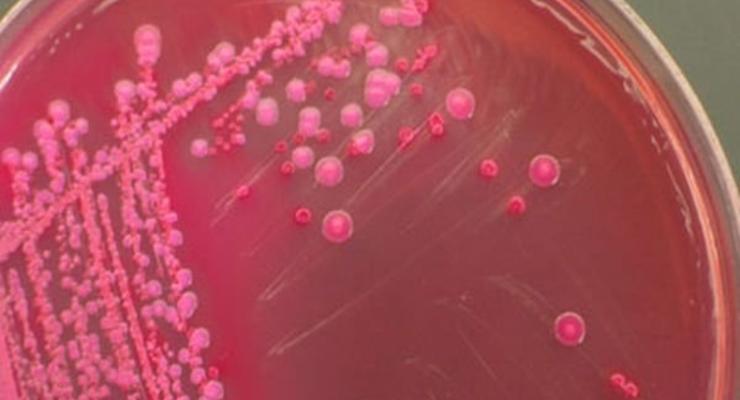
101872

Kâbusa Dönüşen Salgın Aylarca Sürebilir
Enstitünün başkanı Reinhard Burger, ayrıca BBC'ye yaptığı açıklamada, "salgının kaynağını asla bulamayabileceklerini de" vurguladı.
Burger, İspanyol çiftçilerin, ürettikleri salatalıkların haksız yere suçlanmasından duyduğu üzüntüyü de dile getirdi. E.koli salgınına şimdiye dek 1500'ü aşkın insan yakalandı. Salgında şimdiye kadar Almanya'da 17, İsveç'te ise 1 kişi hayatını kaybetti.
E.koli, ölümle sonuçlanabilecek hemolik üremik sendrom HÜS'e yol açıyor. HÜS, bir çok vakada, mide bağırsak enfeksiyonu, böbreklerde sorun yaratıyor. Hamburg'daki kliniklerde yaratan HÜS hastalarının yaklaşık yarısı, hastalandıktan 3-5 gün sonra, epilepsi nöbeti ve konuşma bozukluğu gibi sinirsel bozukluklar sergilediler. Alman yetkililer, yaptıkları incelemelerin, bu kişilerin salatalık, domates ve marul gibi çiğ sebze yiyerek enfeksiyon kaptıklarını gösterdiğini belirtiyorlar.
Bu arada Rusya, Avrupa Birliği ülkelerinden gelen tüm sebze ithalatını yasakladı. AB ülkelerinden ihraç edilen sebzelerin dörtte biri Rusya'ya gönderiliyor.
SALGININ KAYNAĞI ARAŞTIRILIYOR
Almanya'da araştırmacılar hala, ölümlere yol açmaya devam eden E.coli bakterisinin kaynağını bulmaya çalışıyorlar. İlk günlerde ölümcül bakterinin İspanya'da üretilen salatalıklardan geçtiği bildirilmişti; ancak daha sonra bu salatalıkların söz konusu bakteriyi taşımadığı anlaşıldı. Bakteriden İspanya salatalıklarından kaynaklanmadığı bilgisi, İspanyol üreticiler açısından çok gecikmeli geldi, ülkenin güneyinde tonlarca yeni toplanmış salatalık imha edildi.
İspanya hükümeti, sebze üreticileri için tazminat talep ederken, Başbakan Yardımcısı Alfredo Perez Rubalcaba, Hamburg yetkililerine karşı yasal girşimde bulunabileceklerini söyledi. Die Welt gazetesi, Almanya'nın kuzeyinde yaşayanların, yörede yetişen sebzeleri bile almadığını yazdı. Almanya'daki Robert Koch Enstitüsü, özellikle Kuzey Almanya'da yaşayan halka çiğ sebze yenmemesi çağrısında bulunmuştu.
SALATALIĞA MASUMMUŞ
AB Komisyonu, Almanya ve İsveç'te ölümlere yol açan E.koli bakterisinin yayılmasına yol açtığından kuşkulanılan İspanyol salatalığıyla ilgili uyarısını bu akşam kaldırdı. Komisyondan yayınlanan açıklamada, İspanya'da üretilen salatalıklar üzerinde Ispanya ve Almanya'da yapılan testlerin, hastalığa yol açan E.koli bakterisinin "0104" sayılı kökünün varlığının bulunmadığını ortaya çıkardığı belirtilerek, Avrupa düzeyinde yapılan uyarının kaldırıldığını kaydetti.
İspanya Sağlık Bakanlığı da, Komisyon'un kararının İspanyol tarım sektörünün mümkün olan en kısa sürede normale dönmesi için çok önemli bir adım olduğunu bildirdi. Bu arada, Avrupa Birliği Komisyonu'nun sağlıktan sorumlu üyesi John Dalli de, AB bünyesinde ciddi bir sağlık krizine yol açan bu salgının kaynağının belirlenmesi için çabalarını arttırması yönünde sıkıştırarak, "Salgının merkezi Hamburg bölgesiyle sınırlı" dedi. (BBC Türkçe)
Yorum Ekle
Diğer Haberler
ABD ordusunda kriz: Terfiler durduruldu, komutanlar tasfiye edildi
ABD Savunma Bakanı Pete Hegseth’in, İran gerilimi sürerken ordu içinde kapsamlı bir tasfiyeye gittiği öne sürüldü. ABD basınına göre çok sayıda üst düzey komutan görevden alındı, bazı sub...
BAE’deki Habşan gaz tesislerine saldırı: Can kaybı var!
Birleşik Arap Emirlikleri’nin başkenti Abu Dabi’deki Habşan gaz tesislerine düzenlenen saldırıda 1 kişinin hayatını kaybettiği bildirildi. Abu Dabi Hükümeti Medya Ofisi’nin sosyal medya h...
Rus savaş uçağı eğitim uçuşu sırasında düştü
Rusya’ya ait bir savaş uçağı, Kırım’da planlı bir eğitim uçuşu sırasında düştü. İlk belirlemelere göre kazada can kaybı yaşanmadı. Rusya Savunma Bakanlığı’nın açıklamasına göre, Sukhoi Su...
Hakan Safi, Fenerbahçe başkanlığı için adaylık şartını açıkladı!
Fenerbahçe'nin eski yöneticisi Hakan Safi, sarı-lacivertli kulübün başkanlığı için aday olma şartını açıkladı. Fenerbahçe'de eski başkan Ali Koç'un yönetimindeki isimlerden olan Hakan Saf...
'O zamanlar Ortadoğu'da petrol veya doğalgaz pompalanmıyordu'
ABD Başkanı Donald Trump’ın İran’ı "Taş Devri’ne döndürme" tehdidine, İran Dışişleri Bakanı Abbas Arakçi, "O zamanlar Orta Doğu'da petrol veya doğalgaz pompalanmıyordu. ABD Başkanı ve onu...
ABD’de Kara Kuvvetleri Komutanı görevden alındı
ABD Savunma Bakanlığı’nın resmi açıklamasında Kara Kuvvetleri Komutanı Randy George'un "derhal emekli olacağı" duyuruldu
ABD-İsrail, İran'daki köprüye saldırdı: İran basını o listeyi yayımladı
İran basını, Kerec kentindeki B1 Köprüsü’ne yönelik ABD-İsrail saldırısının ardından bölge ülkelerinde bulunan önemli köprülerin listesini yayımlayarak misilleme imasında bulundu.
Macron, Trump’ın planını reddetti: Gerçekçi değil
Fransa Cumhurbaşkanı Emmanuel Macron, ABD Başkanı Donald Trump’ın Hürmüz Boğazı’na askeri müdahale çağrısını “gerçekçi değil” diyerek reddetti. Macron, çözümün askeri değil, ateşkes ve di...
Bulut hırsızlığı ve 'yağmurları çalmak' mümkün mü?
İklim silahlarına dair komplo teorilerinin arttığı bir dönemde, 'yağmur üretme' uygulamaları dünya genelinde yeniden gündemde. Yöntemlerin etkinliğine dair kanıtlar şimdilik sınırlı kalır...
SOSYAL MEDYA
MAGAZİN
Doğa Rutkay: Çocuğum olmasını hiç istemedim
DOĞA Rutkay, “Yasemin’in Penceresi” adlı programa konuk oldu. 2014 yılında Kerimcan Kamal’la evlenen, 2018 yılında da Piraye ve Rutkay Kerim adlı ikiz çocuklarını dünyaya getiren ünlü oyu...
TEKNOLOJİ
EDİTÖR'ÜN SEÇTİKLERİ
‘Çocuklarda iletişim sorunları otizmin ilk işareti olabilir’
Çocuklarda erken yaşlarda ortaya çıkan iletişim ve sosyal etkileşim sorunlarının otizmin ilk belirtileri arasında yer alabileceğini belirten uzmanlar, ailelerin çocuklarının gelişim sürecini dikkatle takip etmesi gerektiğini vurguluyor. Çocuk ve Ergen Psikiyatrisi Uzmanı Dr. Umut Balatacı, özellikle erken çocukluk döneminde görülen bazı davranışsal farklılıkların erken tanı açısından önemli ipuçları verebileceğini söyledi.










































Yorumlar
Bu haberde yorum bulunmamaktadir.